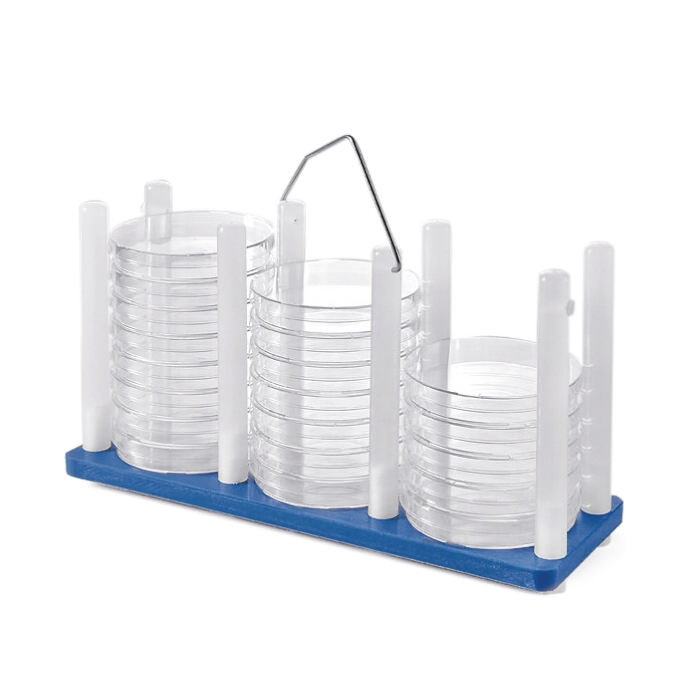

Statywy i nosidła na szalki Petriego
-
Pojemniki do sterylizacji szalek Petriego 480,00 zł – 790,00 zł
Z nierdzewnej stali szlachetnej 18/8. Ze stelażem do szalek o śr. do 100 mm. Można sterylizować w temperaturze do +150°C.
-
Statywy na szalki Petriego 166,95 zł – 195,07 zł
Statyw metalowy z rączką przeznaczony na ok. dziesięć szalek o średnicy do 100 mm.
-
Statywy na szalki Petriego - z uchwytem LabRacks 380,00 zł – 395,66 zł
Statywy na szalki Petriego – z polipropylenu (PP), wyposażone w uchwyty. Wykorzystywane do wygodnego przenoszenia większych ilości płytek Petriego. Wykonane z dobrej jakości tworzywa, mogą być autoklawowalne.
-
Statywy DishRack do szalek Petriego Sarstedt 98,40 zł – 411,72 zł
Statywy DishRack przeznaczone do przechowywania i transportu szalek Petriego o śr. 92-100 mm. Wykonane z PC. Odporne chemicznie i termicznie. Autoklawowalne. DishRack 50 może pomieścić 52 szalki, natomiast w statywie DishRack 80 można przechowywać 88 szalek.
Statywy DishRack do szalek PetriegoSarstedt 98,40 zł – 411,72 zł -
Pojemnik na szalki Petriego Heathrow Scientific 442,07 zł
Pojemnik na szalki Petriego przystosowany do ustawienia na stole lub do montażu na ścianie. Wykonany ze szkła akrylowego. Stabilny i wygodny w użyciu. Posiada dwie przegrody na ok. 28 szalek Petriego o maks. śr. 97 mm.
-
Stojaki PetriPile® ze stali nierdzewnej Interscience 491,49 zł – 759,38 zł
Praktyczne stojaki przeznaczone do przechowywania i bezpiecznego przenoszenia szalek Petriego. Wykonane ze stali nierdzewnej. Przeznaczone do przechowywania 36 szalek o różnej średnicy (16 szalek dla Ø 150 mm). Z możliwością ustawiania piętrowego. Autoklawowalne.
Stojaki PetriPile® ze stali nierdzewnejInterscience 491,49 zł – 759,38 zł -
Tacka inkubacyjna na szalki Petriego Bel-Art 180,97 zł
Tacka inkubacyjna zwiększająca całkowitą pojemność inkubatora, ułatwiająca organizację i umożliwiająca wygodne przenoszenie szalek Petriego. Otwory wentylacyjne umieszczone w dnie ułatwiają przepływ powietrza. Boczne ścianki można wykorzystać do identyfikacji próbek za pomocą markera lub etykiety.
Miniatura Nr-art. Nazwa Szerokość Długość Wysokość Cena netto Ilość 
2-1306 Tacka inkubacyjna na szalki Petriego 237 mm 251 mm 35 mm 180,97 zł -+Tacka inkubacyjna na szalki PetriegoBel-Art 180,97 zł